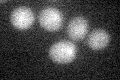

View description
Mitochondrial inner membrane localized ATP-dependent DNA helicase, required for the maintenance of the mitochondrial genome; not required for mitochondrial transcription; has homology to E. coli helicase uvrD
Localization:
Intensity:
Fold change:
Significance:
-
C’ GFP library in SD

cytosol19.23 -
N' NOP1pr-GFP in SD

mitochondria51.5013 -
N' TEF2pr-mCherry in SD

mitochondria49.2294 -
N' NATIVEpr-GFP in SD

mitochondria21.8669 -
N' TEF2pr-VC and Cyto-VN in SD

below threshold23.3218 -
C’ GFP library in SD+DTT

cytosol15.530.8No -
C’ GFP library in SD+H2O2

cytosol22.721.18No -
C’ GFP library in Starvation Media
cytosol17.910.93No -
C’ GFP library on the background of Pup2-DaMP

cytosol -
C’ GFP library on the background of CCT mutant

cytosolN/AN/ANo
